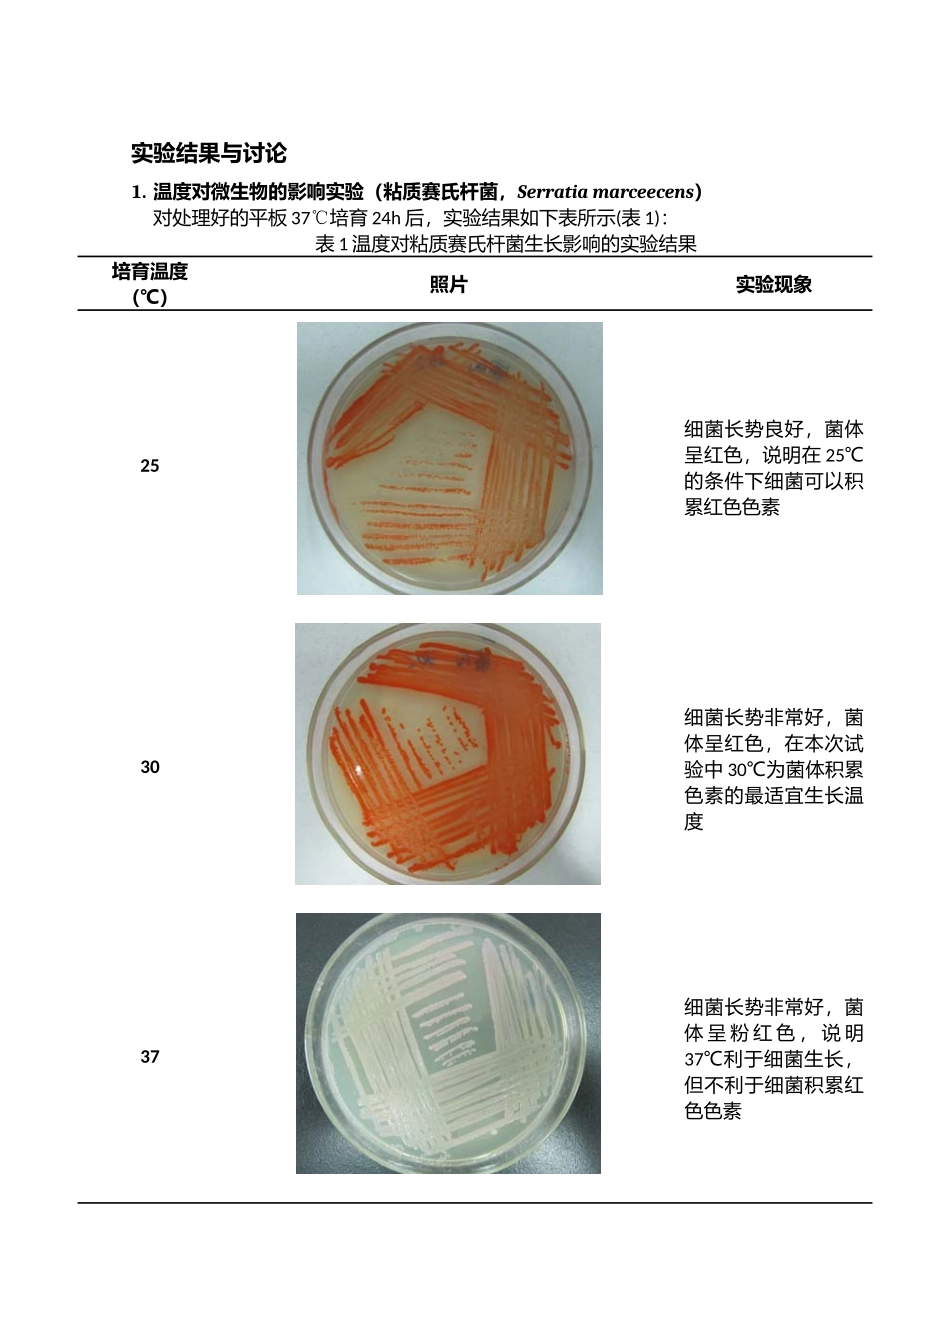
环境因素对微生物的影响和紫外诱变效应_第3页

环境因素对微生物的影响和紫外诱变效应生 72 伍国羽 2025012357组别 周四班 2-1-1实验同组人:王甦实验时间 2025 年 5 月 6 日实验目的1) 了解物理因素、化学因素及生物因素抑制或杀死微生物的作用及其试验方法
2) 了解紫外线诱变原理,并初步掌握紫外线诱变育种的方法
3) 练习单菌落划线分离微生物
实验原理在自然界中,微生物分布极其广泛,几乎无处不在,微生物的生长发育受着环境因素的影响
而不同的微生物及微生物不同的生理状态受环境因素影响的程度也不同,有的环境因素是微生物生长繁殖所必需的条件,有的表现为抑制作用,有的表现为杀菌作用
温度通过影响蛋白质、核酸等生物大分子的结构与功能以及细胞结构来影响微生物的生长、繁殖和新陈代谢
微生物群体生长、繁殖最快的温度为其最适生长温度,但它并不等于积累某一代谢产物的最适温度
粘质沙雷氏菌能产生红色或紫红色色素,菌落表面颜色随着色素量的增加呈现出由橙黄到深红色逐渐加深的变化趋势
常用的化学消毒剂主要包括重金属及其盐类、有机溶剂(酚、醇、醛等)、卤族元素及其化合物和表面活性剂等
根据是杀死还是抑制微生物,可分为致死剂和抑制剂
常用的3 个指标:最低抑制浓度(MIC)、半致死剂量和最低致死剂量
许多微生物在其生命活动过程中能产生某种特别代谢产物如抗生素,具有选择性地抑制或杀死其他微生物的作用
不同抗生素的抗菌谱是不同的,某些抗生素只对少数细菌有抗菌作用
产黄青霉分泌青霉素抑制细菌细胞壁的合成
青霉素主要抗 G+细菌
链霉素作用于核糖核酸 30S 亚基,所以链霉素只作用原核生物
链霉素以抗 G-细菌为主
紫外线具有杀菌作用主要是因为它诱导形成胸腺嘧啶二聚体来破坏 DNA 的结构,使其不能正常行使功能
另外,空气在紫外线照射下产生臭氧(O3),也有一定杀菌作用
紫外线杀菌力最强的波长是 226-256nm 部分